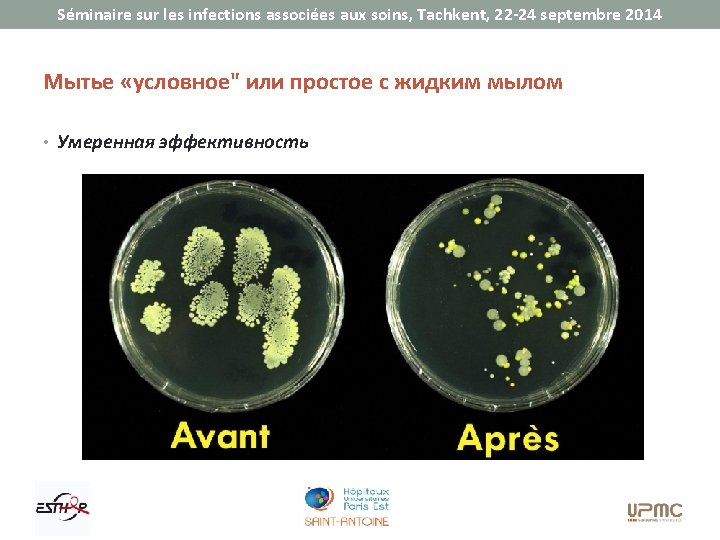
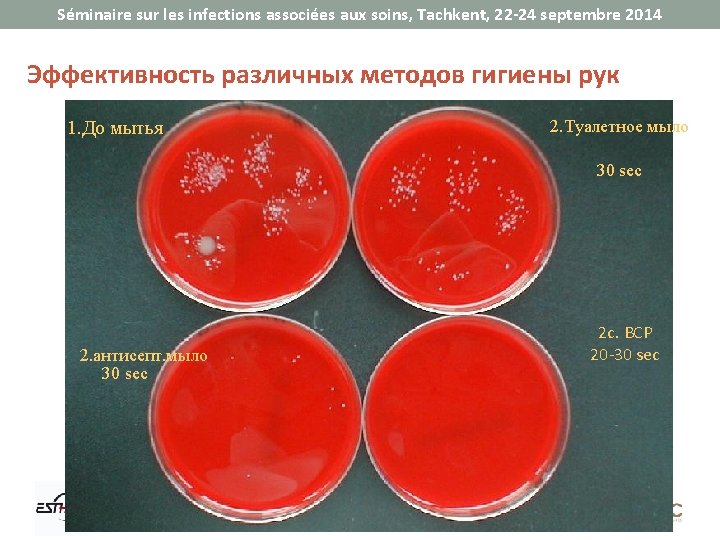

Sminaire sur les infections associes aux soins Tachkent

















































- Slides: 49


Séminaire sur les infections associées aux soins, Tachkent, 22 -24 septembre 2014 История • 1847: Опыт Semmelweiss • Мытье рук снижает количество смертей от родильной горячки Chlorure de chaux à 4%









Séminaire sur les infections associées aux soins, Tachkent, 22 -24 septembre 2014 Влияние распространения информации о гигиене рук Anné e Lieu Augmentation de l’observance à l’hygiène des mains Diminution des taux d’infections associées aux soins (IAS) Suivi Référence 1989 SI adultes de 14% à 73% (av. contact patient) taux des IAS : de 33% à 10% 6 ans Conly et al 2000 hôpital de 48% à 66% prévalence des IAS : de 16, 9% à 9, 5% 8 ans Pittet et al 2004 SI néonatals de 43% à 80% incidence des IAS : de 15, 1 à 10, 7/1000 journées-patient 2 ans Won et al 21 mois Rosenthal et al 4 ans Zerr et al 27 mois Pessoa-Silva et al 2 ans Thu et al 1) 2 an s 2) 1 an Grayson et al 2005 SI adultes de 23, 1% à 64, 5% incidence des IAS : de 47, 5 à 27, 9/1000 journées-patient 2005 hôpital de 62% à 81% réduction significative des infections à rotavirus 2007 néonatologie de 42% à 55% incidence des IAS: globalement, de 11 à 8, 2 infections/ 1000 journées-patient et chez les nouveau-nés de très faibles poids de 15, 5 to 8, 8 infections /1000 journées-patient 2007 neurochirurgie 2008 1) 6 établissements pilotes 2) tous les établissements de soins de Victoria (Australie) sans objet 1) de 21% à 48% 2) de 20% à 53% taux des ISC : de 8, 3% à 3, 8% bactériémies SARM : 1) De 0, 05 à 0, 02/100 sorties de patients par mois 2) De 0, 03 à 0, 01/100 sorties de patients par mois

Séminaire sur les infections associées aux soins, Tachkent, 22 -24 septembre 2014 Соблюдение гигиены рук <40% Auteurs Année Secteur Observance Preston 1981 Services généraux Soins Intensifs 16% 30% Albert 1981 Soins Intensifs 41% 28% Larson 1983 Hôpital 45% Donowitz 1987 SI néonatals 30% Graham 1990 Soins Intensifs 32% Dubbert 1990 Soins Intensifs 81% Pettinger 1991 SI chirurgicaux 51% Larson 1992 Service néonatal 29% Doebbeling 1992 Soins Intensifs 40% Zimakoff 1993 Soins Intensifs 40% Meengs 1994 Urgences 32% Pittet 1999 Hôpital 48% Pittet and Boyce. Lancet Infectious Diseases 2001




Séminaire sur les infections associées aux soins, Tachkent, 22 -24 septembre 2014 Рабочая нагрузка и недостаточное соблюдение гигиены рук Индекс активности* Количество случаев (%) Соблюдение OR (IC 95%) < 20 473 (17) 58% 1, 00 21 - 40 1258 (44) 51% 1, 33 (1, 01 – 1, 74) 41 - 60 825 (29) 40% 2, 10 (1, 50 – 2, 93) > 60 278 (10) 37% 2, 12 (1, 28 – 3, 53) * nombre d’opportunités par heure de soins D. Pittet, Lancet 2000

Séminaire sur les infections associées aux soins, Tachkent, 22 -24 septembre 2014 Мытье «условное" или простое с жидким мылом 30




Séminaire sur les infections associées aux soins, Tachkent, 22 -24 septembre 2014 Сравнительная таблица эффективности антисептиков для гигиены рук Efficacité % 0 50 90 99 99, 9 [Rotter 1995]

Séminaire sur les infections associées aux soins, Tachkent, 22 -24 septembre 2014 Эффективность программы для ЛПУ с целью улучшить соблюдение гигиены рук Pittet Д. , Lancet, 2000, 356, 1307 -1312. • Hôpital de Genève (déc. 94 - déc. 97) Fig. 1. Hand-hygiene compliance trend during seven consecutive hospital-wide surveys, University of Geneva Hospitals, 1994– 97 Fig. 3. Trends in prevalence of nosocomial infections and annual attack rate of MRSA, 1993– 98, University of Geneva Hospitals (consomption of alcohol based handrub increased from 3. 5 to 15. 4 l per 1000 patients days)

Séminaire sur les infections associées aux soins, Tachkent, 22 -24 septembre 2014 Эффективность программы для ЛПУ с целью улучшения соблюдения гигиены рук Pittet D. , Lancet 2000, 356, 1307 -1312

Séminaire sur les infections associées aux soins, Tachkent, 22 -24 septembre 2014 Эффективность программы обучения Bataillon et coll. , JHI 2010 2006 2007 p Полное соответствие правилам 44, 0 58, 0 <0, 001 Частичное соответствие правилам 73, 5 88, 4 <0, 001 Без соответствия 26, 3 11, 6 Hygiène des Mains - 2010





Séminaire sur les infections associées aux soins, Tachkent, 22 -24 septembre 2014 Водно-спиртовая обработка: как ? Специальная тактика

Séminaire sur les infections associées aux soins, Tachkent, 22 -24 septembre 2014 Важность качественной обработки рук



Séminaire sur les infections associées aux soins, Tachkent, 22 -24 septembre 2014


Séminaire sur les infections associées aux soins, Tachkent, 22 -24 septembre 2014 121 страна присоединилась к профилактике инфекций, связанных с медобслуживанием, в том числе 87% всего населения Situation Août 2009 Perspective as of 5 May 2009

Séminaire sur les infections associées aux soins, Tachkent, 22 -24 septembre 2014 Back up : NE PAS TRADUIRE LES DIAPOS QUI SUIVENT



Séminaire sur les infections associées aux soins, Tachkent, 22 -24 septembre 2014 Антибактериальную эффективность Исследование загрязнения до и после гигиены рук Contamination bactérienne Avant Après Savon doux 10 s 1, 49 0, 75 Savon doux 30 s 1, 40 0, 89 Savon désinfectant 10 s 1, 60 0, 47 Savon désinfectant 30 s 1, 46 0, 33 Savon désinfectant 60 s 1, 48 0, 28 SHA 1, 53 0, 132002 J. C. Lucet Hygiène des Mains - 2010 SP HH Evaluation - CHU Brest 47

Séminaire sur les infections associées aux soins, Tachkent, 22 -24 septembre 2014 Влияние продолжительности Durée LM avec savon désinfectant 1 à 1, 5 mn SHA 15 à 20 sec Efficacité 15 à 20 sec 30 sec LM SD 0, 8 1, 8 – 2, 8 SHA 3 0, 5 3, 2 – 5, 8 Hygiène des Mains - 2010 SP HH Evaluation - CHU Brest Rotter, 1999; Pittet, 1999 48

Séminaire sur les infections associées aux soins, Tachkent, 22 -24 septembre 2014